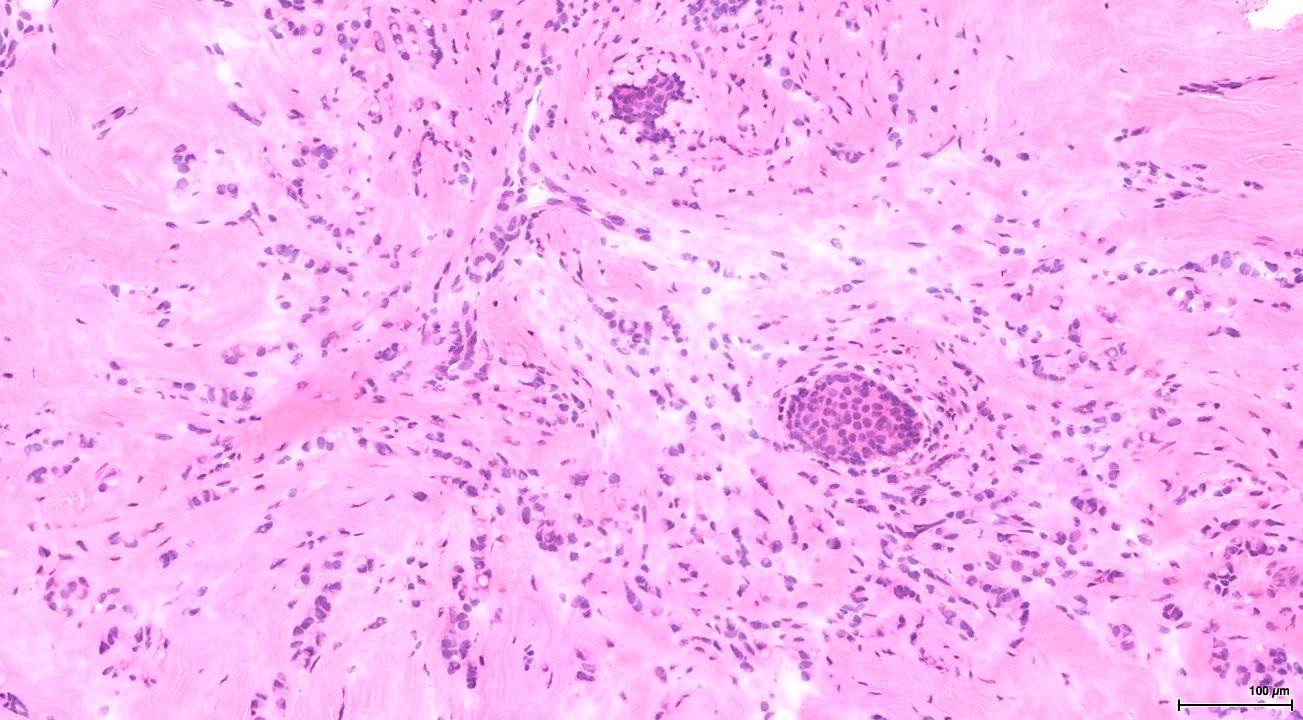
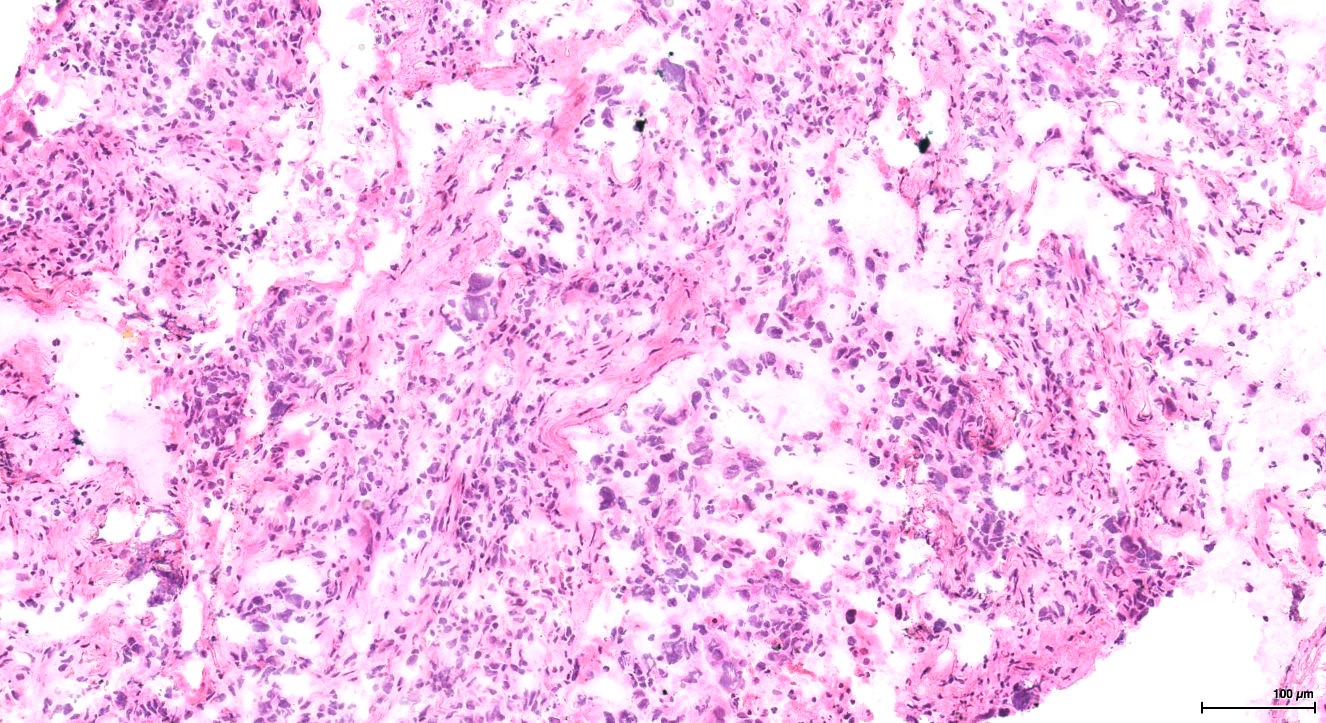

Cancer remains a global health challenge, necessitating innovative diagnostic approaches for early detection and understanding the underlying metabolic processes. Recent studies have uncovered links between cancerous tissue and depleted nitrogen isotope ratios (15N/14N) compared to healthy tissues, suggesting potential applications in diagnosis and cancer metabolism research. Limiting in most studies so far is the measurement sensitivity and design of sample selection. Traditional mass spectrometry methods require several mg of sample material. This poses a problem as biopsies contain many different components (i.e., samples do not consist of 100 % tumor cells and interferences with isotopic signatures of other components are likely). Most studies compared cohorts of cancer patients with cohorts of healthy patients, introducing biases from base line signatures in naturally occurring nitrogen isotopes. To overcome these limitations, we use a new high-resolution sampling method and a high-sensitivity analytical technique, enabling us to measure minute quantities of N. Our research focuses on studying nitrogen isotope ratios of diverse human cancers in individual patients to investigate the relationship between tumor types and grade, and effects on cellular nitrogen metabolism. An improved understanding of malignant cell nitrogen metabolism is central to an understanding-based attack on cancer and development of possible treatment strategies.
This study is funded by Schweizerischer Nationalfonds, Beitrag Nr. 10.001.887, 2025-2029